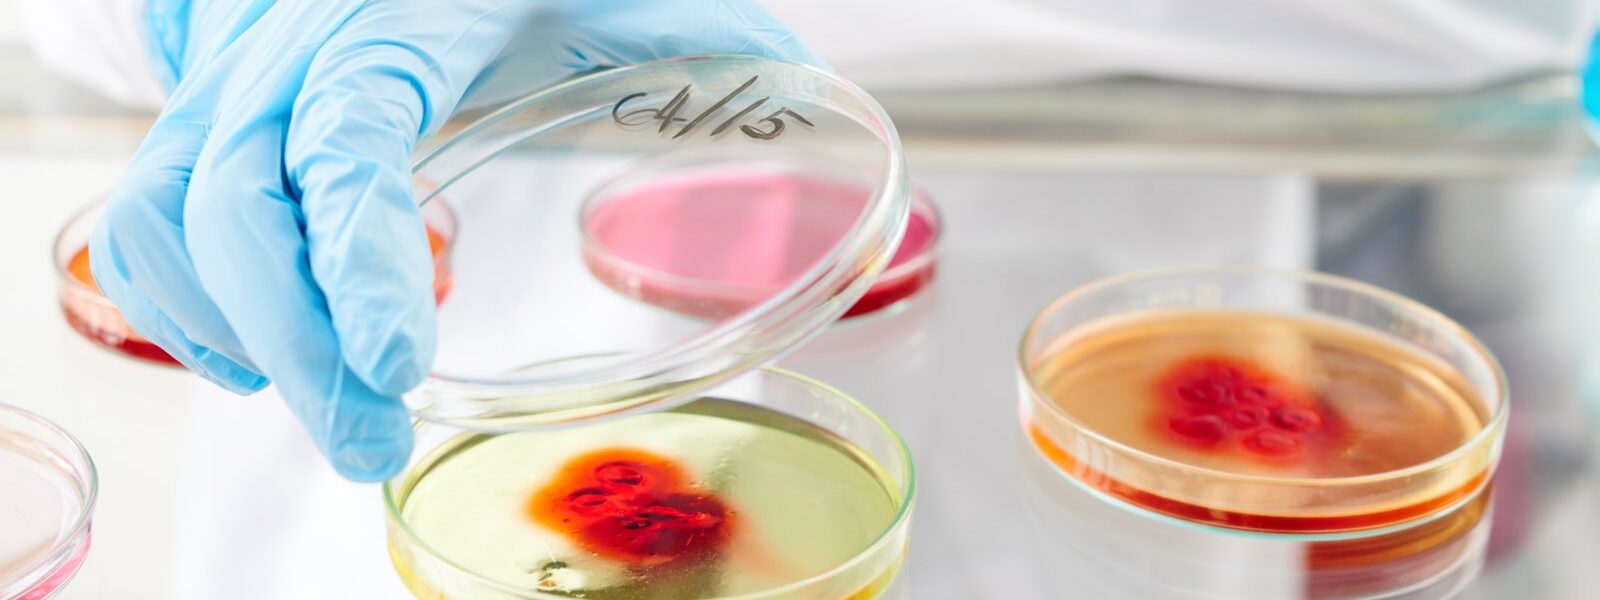

Komórki macierzyste od kilku dekad fascynują środowisko naukowe i medyczne. Ich unikalna zdolność do przekształcania się w różne typy komórek ciała sprawia, że są postrzegane jako przyszłość terapii regeneracyjnych. W odróżnieniu od dojrzałych komórek organizmu, komórki macierzyste potrafią nie tylko się różnicować, ale również samoodnawiać. To oznacza, że mogą teoretycznie zastępować uszkodzone lub chore tkanki, oferując nową drogę w leczeniu wielu chorób, których współczesna medycyna nie była dotąd w stanie skutecznie zwalczyć.
Rodzaje komórek macierzystych
Zasadniczo wyróżniamy kilka typów komórek macierzystych, różniących się potencjałem rozwojowym. Najbardziej wszechstronne są komórki embrionalne, które mogą przekształcać się we wszystkie typy komórek ciała. Z kolei komórki macierzyste dorosłego organizmu – obecne m.in. w szpiku kostnym – wykazują ograniczoną zdolność różnicowania, ale są łatwiejsze do pozyskania i nie budzą kontrowersji etycznych. W ostatnich latach przełomem okazały się tzw. komórki iPS – indukowane pluripotencjalne komórki macierzyste, które powstają w laboratorium poprzez „przeprogramowanie” dojrzałych komórek pacjenta.
Zastosowania kliniczne i potencjał terapeutyczny
Najbardziej znanym zastosowaniem komórek macierzystych jest przeszczep szpiku kostnego – standardowa procedura w leczeniu białaczek i innych chorób krwi. Jednak możliwości ich użycia są znacznie szersze. Trwają intensywne badania nad wykorzystaniem komórek macierzystych do regeneracji uszkodzonych serc po zawale, odbudowy tkanki nerwowej u pacjentów z urazami rdzenia kręgowego, a nawet leczenia cukrzycy typu 1 poprzez odbudowę komórek beta w trzustce. Coraz więcej ośrodków naukowych rozwija także techniki wytwarzania sztucznych narządów, bazując na hodowlach komórkowych pacjenta.
Biotechnologia jako fundament postępu
Rozwój terapii komórkowych nie byłby możliwy bez zaawansowanej biotechnologii. To właśnie dzięki niej możliwe jest precyzyjne hodowanie komórek w kontrolowanych warunkach laboratoryjnych, ich różnicowanie oraz przygotowanie do wszczepienia pacjentowi. Biotechnologia medyczna łączy osiągnięcia biologii molekularnej, inżynierii genetycznej i materiałoznawstwa. Kluczowe znaczenie mają także nośniki komórkowe, matryce i biokompatybilne żele, które pozwalają komórkom prawidłowo funkcjonować po implantacji.
Wyzwania i ograniczenia terapii komórkowych
Pomimo ogromnego potencjału, wykorzystanie komórek macierzystych wiąże się również z istotnymi wyzwaniami. Jednym z nich jest ryzyko niekontrolowanego podziału i powstania zmian nowotworowych – szczególnie w przypadku komórek embrionalnych i iPS. Kolejnym problemem jest kwestia immunologicznej zgodności komórek z organizmem pacjenta. Wiele terapii wymaga ścisłego dopasowania genetycznego, aby uniknąć odrzutu. Również proces produkcji i przechowywania komórek jest kosztowny i wymaga wysoce specjalistycznego zaplecza.
Nowoczesne technologie wspierające rozwój terapii
Jednym z kierunków rozwoju jest integracja terapii komórkowych z nanomedycyną. Dzięki nanotechnologii możliwe jest dostarczanie czynników wzrostu i leków bezpośrednio do hodowli komórkowych lub miejsc uszkodzenia tkanek. Nanomedycyna pozwala również zwiększyć precyzję manipulacji na poziomie molekularnym, co podnosi skuteczność i bezpieczeństwo terapii. W połączeniu z algorytmami sztucznej inteligencji i modelowaniem komputerowym, komórki macierzyste stają się częścią nowej epoki spersonalizowanej medycyny.
Komórki macierzyste a żywność funkcjonalna
Choć może się to wydawać zaskakujące, technologie związane z komórkami macierzystymi znajdują także zastosowanie w produkcji żywności. Biotechnolodzy eksperymentują z hodowlą mięsa in vitro, wykorzystując komórki macierzyste zwierząt, aby stworzyć alternatywy dla tradycyjnej hodowli. Produkcja żywności przyszłości oparta na hodowlach komórkowych ma szansę ograniczyć emisje gazów cieplarnianych, zmniejszyć zużycie wody i zwiększyć bezpieczeństwo mikrobiologiczne produktów spożywczych. Choć ten segment dopiero się rozwija, jest dowodem na uniwersalność komórek macierzystych jako technologii zmieniającej wiele obszarów życia.
Kierunek przyszłości czy ostrożny eksperyment?
Komórki macierzyste pozostają jednym z najintensywniej badanych narzędzi współczesnej medycyny. Łączą ogromny potencjał regeneracyjny z realnymi wyzwaniami etycznymi, technologicznymi i klinicznymi. Ich przyszłość zależy zarówno od dalszego rozwoju nauki, jak i od wprowadzenia odpowiednich regulacji prawnych i standardów bezpieczeństwa. Jeśli uda się przezwyciężyć obecne ograniczenia, komórki macierzyste mogą zrewolucjonizować leczenie, profilaktykę, a nawet codzienne życie pacjentów. W świecie starzejącego się społeczeństwa i rosnących potrzeb zdrowotnych, stają się nie tylko tematem badań, ale i strategiczną nadzieją.